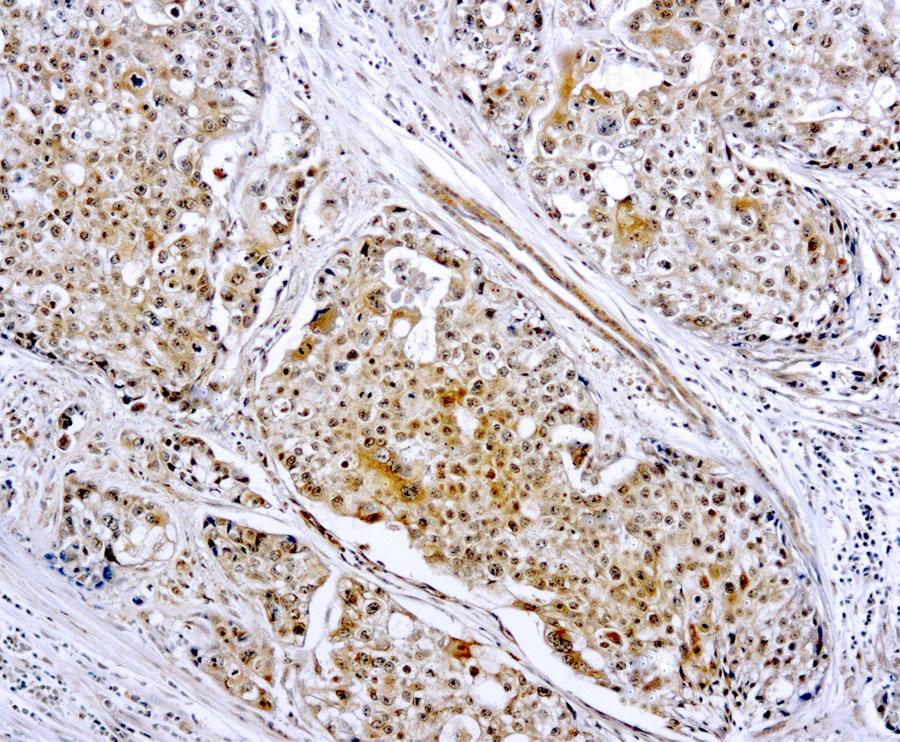

Rabbit Polyclonal Antibody to MMP-9(Discontinued)
Figure 1 : Formalin fixed paraffin embedded human breast carcinoma stained with MMP-9 antibody ( 10-11545).
Roll over image to zoom in

Shipping Info:
For estimated delivery dates, please contact us at [email protected]
Format : | Purified |
Amount : | 0.5 ml |
Isotype : | Rabbit IgG |
Content : | Purified immunoglobulin fraction of rabbit antiserum against human MMP-9 containing sodium azide as preservative. |
Storage condition : | Store at 2-8°C. |
This antibody reacts with a 92 kDa pro form and 86 kDa active form of MMP-9. MMPs are proteolytic enzymes capable of degrading connective tissue components. MMPs play a crucial role in tumor cell invasion and metastasis.
IHC : 1:25-1:50
For Research Use Only. Not for use in diagnostic/therapeutics procedures.
Subcellular location: | Secreted |
Post transnational modification: | N- and O-glycosylated. |
Tissue Specificity: | Detected in neutrophils (at protein level) (PubMed:7683678). Produced by normal alveolar macrophages and granulocytes. |
BioGrid: | 110461. 18 interactions. |
There are currently no product reviews
|